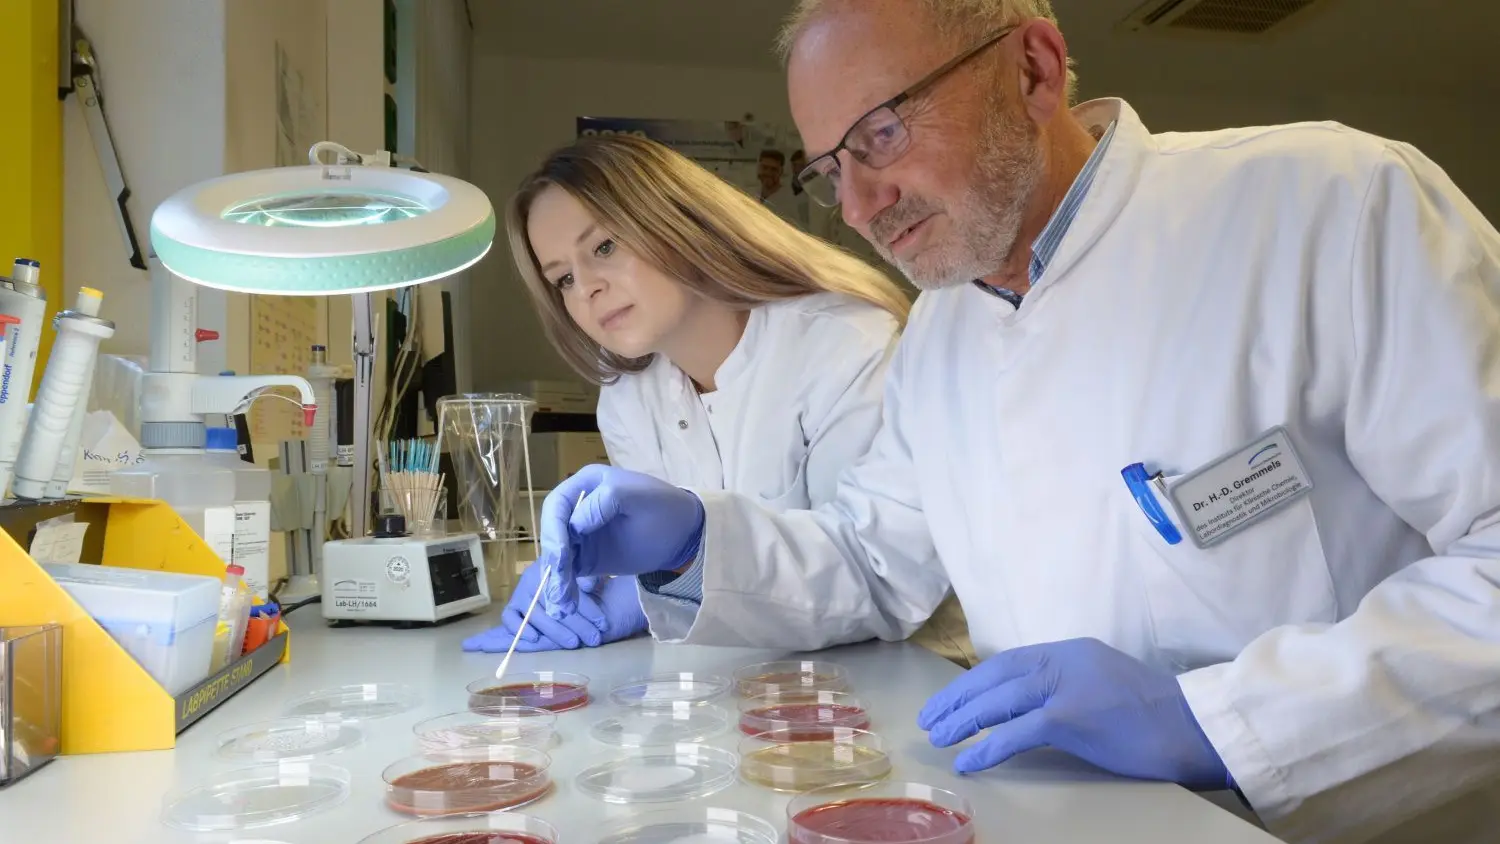

Antikörperstudie am Klinikum Niederlausitz: Hält der Impfschutz gegen das Corona-Virus auch im Herbst?
Das Klinikum Niederlausitz hat eigene Antikörperstudien durchgeführt um herauszufinden, wann die Wirkung der Corona-Impfung nachlässt. Die Ergebnisse überraschen. Das raten die Experten aus Senftenberg.
Dr. Heinz Detlef Gremmels (v.) und Juliane Schiebel aus dem Institut für Labordiagnostik im Klinikum Niederlausitz beschäftigen sich mit Krankheitserregern und deren Verbreitung. Für die umfangreiche Studie rund um die Antikörperentwicklung nach Impfungen oder Erkrankungen mit dem Coronavirus wurden im Institut mehr als 4000 Blutproben zentrifugiert und untersucht.
Steffen Rasche